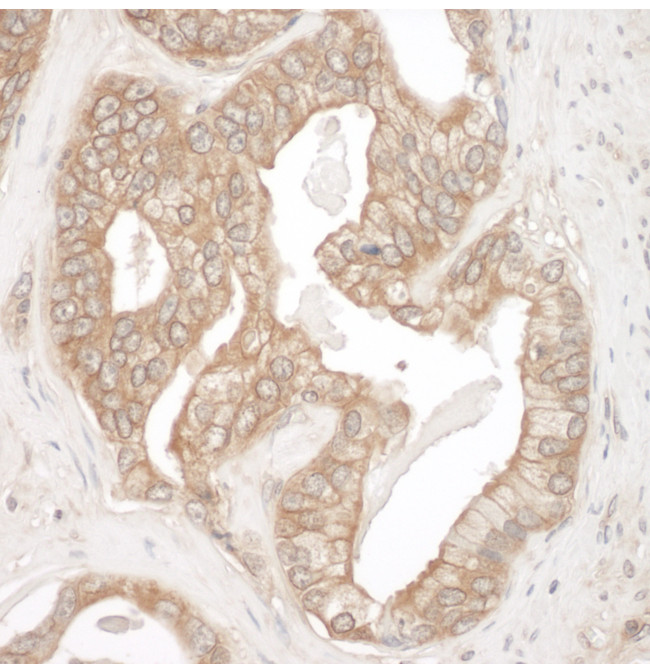
Cortactin Antibody in Immunohistochemistry (Paraffin) (IHC (P))

Search
Bethyl Laboratories
Cortactin Polyclonal Antibody
{{$productOrderCtrl.translations['antibody.pdp.commerceCard.promotion.promotions']}}
{{$productOrderCtrl.translations['antibody.pdp.commerceCard.promotion.viewpromo']}}
{{$productOrderCtrl.translations['antibody.pdp.commerceCard.promotion.promocode']}}: {{promo.promoCode}} {{promo.promoTitle}} {{promo.promoDescription}}. {{$productOrderCtrl.translations['antibody.pdp.commerceCard.promotion.learnmore']}}
产品信息
A302-608A
种属反应
宿主/亚型
分类
类型
抗原
偶联物
形式
浓度
规格
纯化类型
保存液
内含物
保存条件
运输条件
产品详细信息
The recommended shelf life for this product is 1 year from date of receipt.
Application Note: For IHC, epitope retrieval with citrate buffer pH 6.0 is recommended for FFPE tissue sections.
靶标信息
Cortactin (Cttn) is a ubiquitous actin-binding protein that was originally identified as a substrate for Src. It contributes to the organization of the actin cytoskeleton and cell shape. Cortactin also plays a role in the formation of lamellipodia and cell migration. It is accumulated in peripheral, actin-enriched structures of cells suggesting that cortactin facilitates actin network formation. Cortactin has four major domains of interest the N-terminal acidic (NTA) and tandem repeats domains and the C-terminal proline-rich and SH3 Domains. NTA associates with the Arp2/3 and WASP complex at F-actin branches. Cortactin is involved in promoting cell motility and invasion, including a critical role in invadopodia, actin rich-subcellular protrusions associated with degradation of the ECM by cancer cells. Cortactin is phosphorylated by src family kinases at Y421, Y466, and Y482 and S405 and S418 that are phosphorylated by Erk family kinases.
仅用于科研。不用于诊断过程。未经明确授权不得转售。
篇参考文献 (0)
生物信息学
蛋白别名: Amplaxin; ems1 sequence (mammary tumor and squamous cell carcinoma-associated (p80/85 src substrate); epididymis secretory sperm binding protein; FLJ34459; Oncogene EMS1; Oncogene SRC8; Src substrate cortactin; src8; unnamed protein product
基因别名: CTTN; EMS1
UniProt ID: (Human) Q14247
Entrez Gene ID: (Human) 2017